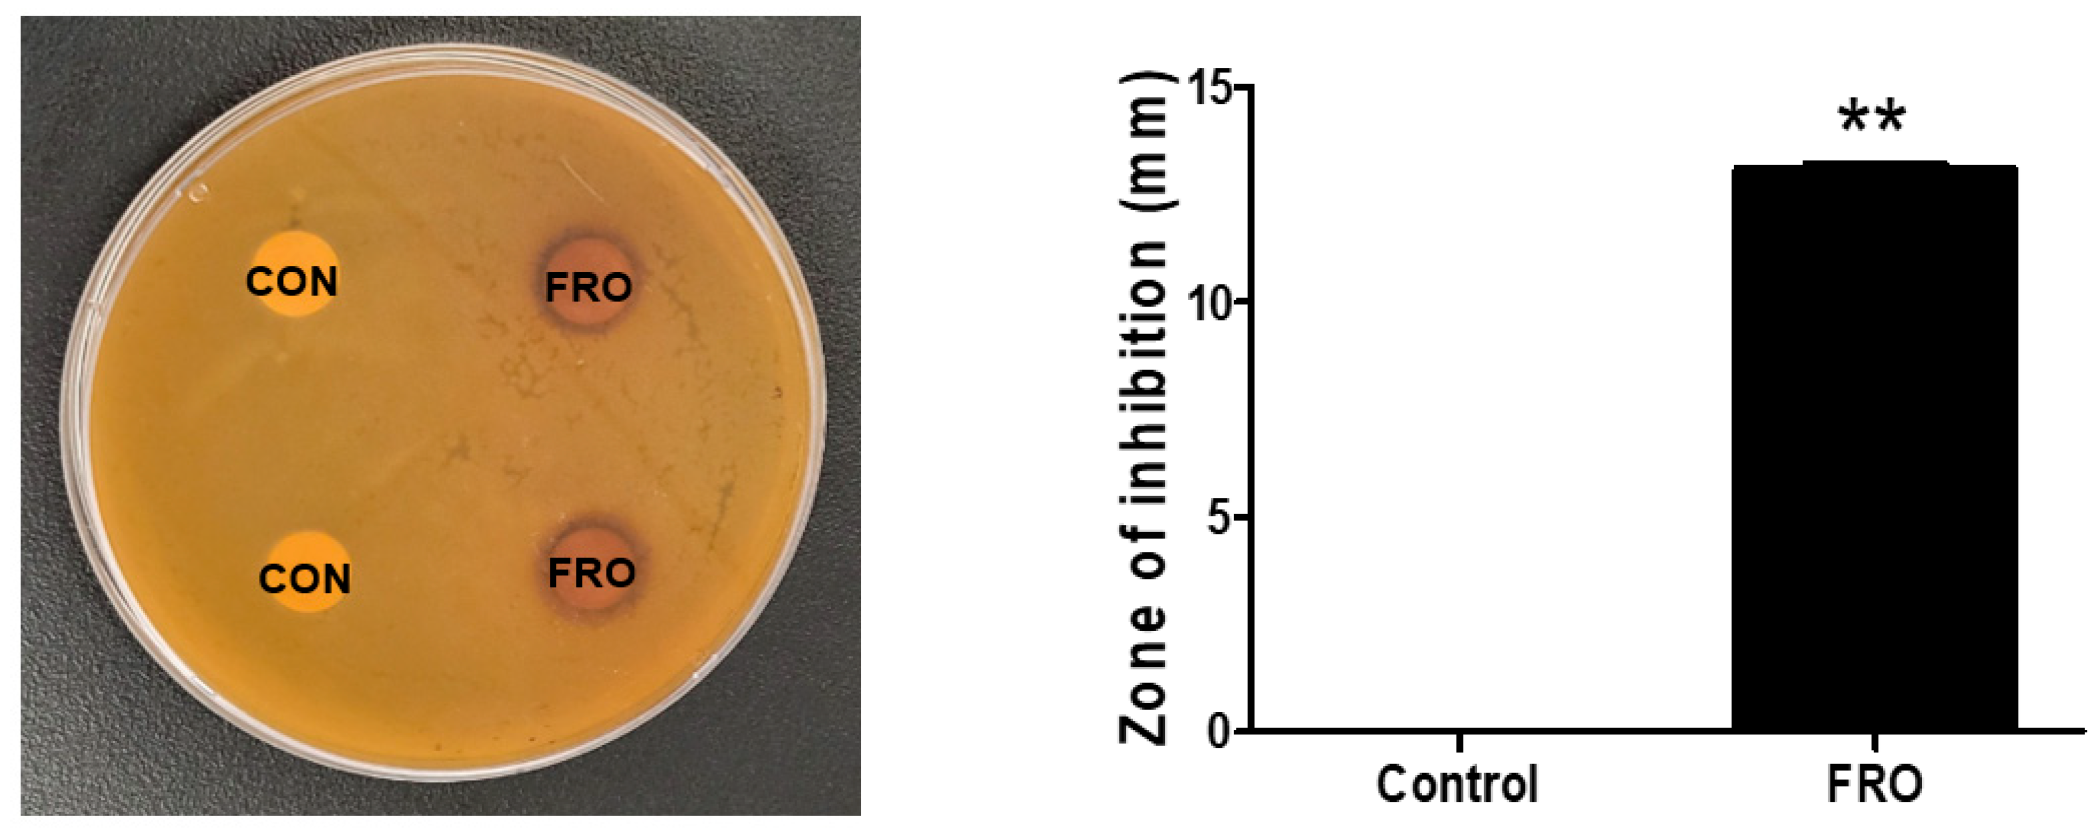

Efficacy of FRO on Acne Vulgaris Pathogenesis
Abstract
1. Introduction
2. Materials and Methods
2.1. FRO Manufacturing
2.2. High-Performance Liquid Chromatography (HPLC)
2.3. Total Phenolic Content
2.4. Disk Diffusion Susceptibility Testing
2.5. Preparation of Heat-Killed C. acnes
2.6. Cell Cultures
2.7. Cell Viability Assay
2.8. Nitric Oxide Evalution
2.9. ROS Assessment
2.10. Western Blot Analysis
2.11. Oil Red O Staining
2.12. Statistical Analysis
3. Results
3.1. FRO Contains Phenolic Compounds
3.2. FRO Has an Antimicrobial Effect against C. acnes
3.3. FRO Suppresses CA- and DHT-Induced Lipid Accumulation in SEB-1 Sebocytes
3.4. FRO Has an Anti-Androgenic and Lipogenic Effect on DHT-Induced LNCaP Cells
3.5. FRO Inhibits Inflammation-Associated Reactive Oxygen Species (ROS) and Nitric Oxides (NO)
3.6. FRO Confers an Anti-Inflammatory Effect by Regulating Two Transcription Factors, STAT-3 and NF-κB
4. Discussion
5. Conclusions
Supplementary Materials
Author Contributions
Funding
Institutional Review Board Statement
Informed Consent Statement
Data Availability Statement
Conflicts of Interest
References
- Ito, M.; Codony-Servat, C.; Karachaliou, N.; Rosell, R. Targeting PKCiota-PAK1 in EGFR-mutation positive non-small cell lung cancer. Transl. Lung Cancer Res. 2019, 8, 667–673. [Google Scholar] [CrossRef] [PubMed]
- Kim, J.-S.; Kwon, Y.-S.; Chun, W.-J.; Kim, T.-Y.; Sun, J.; Yu, C.-Y.; Kim, M.-J. Rhus verniciflua Stokes flavonoid extracts have anti-oxidant, anti-microbial and α-glucosidase inhibitory effect. Food Chem. 2010, 120, 539–543. [Google Scholar] [CrossRef]
- Kim, K.H.; Moon, E.; Choi, S.U.; Kim, S.Y.; Lee, K.R. Polyphenols from the bark of Rhus verniciflua and their biological evaluation on antitumor and anti-inflammatory activities. Phytochemistry 2013, 92, 113–121. [Google Scholar] [CrossRef] [PubMed]
- Lee, G.-S.; Lee, H.-S.; Kim, S.-H.; Suk, D.-H.; Ryu, D.-S.; Lee, D.-S. Anti-cancer activity of the ethylacetate fraction from Orostachys japonicus for modulation of the signaling pathway in HepG2 human hepatoma cells. Food Sci. Biotechnol. 2014, 23, 269–275. [Google Scholar] [CrossRef]
- Kim, J.H.; Nam, G.S.; Kim, S.H.; Ryu, D.S.; Lee, D.S. Orostachys japonicus exerts antipancreatic cancer activity through induction of apoptosis and cell cycle arrest in PANC-1 cells. Food Sci. Nutr. 2019, 7, 3549–3559. [Google Scholar] [CrossRef]
- Kwon, J.-H.; Kim, J.-H.; Ryu, D.-S.; Lee, H.-J.; Lee, D.-S. Anticancer Effect of the Ethyl Acetate Fraction from Orostachys japonicus on MDA-MB-231 Human Breast Cancer Cells through Extensive Induction of Apoptosis, Cell Cycle Arrest, and Antimetastasis. Evid.-Based Complement. Altern. Med. eCAM 2019, 2019, 8951510. [Google Scholar] [CrossRef]
- Lee, K.S.; Kim, S.W.; Lee, H.S. Orostachys japonicus induce p53-dependent cell cycle arrest through the MAPK signaling pathway in OVCAR-3 human ovarian cancer cells. Food Sci. Nutr. 2018, 6, 2395. [Google Scholar] [CrossRef]
- Ryu, D.-S.; Lee, H.-S.; Lee, G.-S.; Lee, D.-S. Effects of the ethylacetate extract of Orostachys japonicus on induction of apoptosis through the p53-mediated signaling pathway in human gastric cancer cells. Biol. Pharm. Bull. 2012, 35, 660–665. [Google Scholar] [CrossRef]
- Cho, H.D.; Lee, K.W.; Won, Y.S.; Kim, J.H.; Seo, K.I. Cultivated Orostachys japonicus extract inhibits VEGF-induced angiogenesis via regulation of VEGFR2 signaling pathway in vitro and in vivo. J. Ethnopharmacol. 2020, 256, 112664. [Google Scholar] [CrossRef]
- Lee, S.G.; Kim, J.S.; Lee, H.S.; Lim, Y.M.; So, J.H.; Hahn, D.; Ha, Y.S.; Nam, J.O. Bioconverted Orostachys japonicas Extracts Suppress Angiogenic Activity of Ms-1 Endothelial Cells. Int. J. Mol. Sci. 2017, 18, 2615. [Google Scholar] [CrossRef]
- Shin, D.Y.; Lee, W.S.; Jung, J.H.; Hong, S.H.; Park, C.; Kim, H.J.; Kim, G.Y.; Hwang, H.J.; Kim, G.S.; Jung, J.M.; et al. Flavonoids from Orostachys japonicus A. Berger inhibit the invasion of LnCaP prostate carcinoma cells by inactivating Akt and modulating tight junctions. Int. J. Mol. Sci. 2013, 14, 18407–18420. [Google Scholar] [CrossRef] [PubMed]
- Kim, Y.I.; Park, S.W.; Yoon, Y.K.; Lee, K.W.; Lee, J.H.; Woo, H.J.; Kim, Y. Orostachys japonicus inhibits the expression of MMP-2 and MMP-9 mRNA and modulates the expression of iNOS and COX-2 genes in human PMA-differentiated THP-1 cells via inhibition of NF-kappaB and MAPK activation. Mol. Med. Rep. 2015, 12, 657–662. [Google Scholar] [CrossRef] [PubMed]
- Kim, S.-H.; Ryu, S.-Y. Antimetastatic effect of several crude drugs with antitumor activity on B16-Fo and A549 cells (I). J. Korean Med. 1996, 17, 111–131. [Google Scholar]
- Lall, N. Medicinal Plants for Holistic Health and Well-Being; Academic Press: Cambridge, MA, USA, 2017. [Google Scholar]
- Cavallo, I.; Sivori, F.; Truglio, M.; De Maio, F.; Lucantoni, F.; Cardinali, G.; Pontone, M.; Bernardi, T.; Sanguinetti, M.; Capitanio, B.; et al. Skin dysbiosis and Cutibacterium acnes biofilm in inflammatory acne lesions of adolescents. Sci. Rep. 2022, 12, 21104. [Google Scholar] [CrossRef] [PubMed]
- US Department of Health Human Services Food Drug Administration Center for Drug Evaluation Research. Guidance for Industry, Acne Vulgaris: Developing Drugs for Treatment; US Department of Health Human Services Food Drug Administration Center for Drug Evaluation Research: Silver Spring, MD, USA, 2005.
- Baldwin, H.; Tan, J. Effects of Diet on Acne and Its Response to Treatment. Am. J. Clin. Dermatol. 2021, 22, 55–65. [Google Scholar] [CrossRef]
- Arora, M.K.; Yadav, A.; Saini, V. Role of hormones in acne vulgaris. Clin. Biochem. 2011, 44, 1035–1040. [Google Scholar] [CrossRef]
- Cordain, L.; Lindeberg, S.; Hurtado, M.; Hill, K.; Eaton, S.B.; Brand-Miller, J. Acne vulgaris: A disease of Western civilization. Arch. Dermatol. 2002, 138, 1584–1590. [Google Scholar] [CrossRef]
- Klinger, B.; Anin, S.; Silbergeld, A.; Eshet, R.; Laron, Z. Development of hyperandrogenism during treatment with insulin-like growth factor-I (IGF-I) in female patients with Laron syndrome. Clin. Endocrinol. 1998, 48, 81–87. [Google Scholar] [CrossRef]
- Kircik, L.H. Advances in the Understanding of the Pathogenesis of Inflammatory Acne. J. Drugs Dermatol. 2016, 15, s7–s10. [Google Scholar]
- O’Neill, A.M.; Gallo, R.L. Host-microbiome interactions and recent progress into understanding the biology of acne vulgaris. Microbiome 2018, 6, 177. [Google Scholar] [CrossRef]
- Ceruti, J.M.; Leiros, G.J.; Balana, M.E. Androgens and androgen receptor action in skin and hair follicles. Mol. Cell. Endocrinol. 2018, 465, 122–133. [Google Scholar] [CrossRef] [PubMed]
- Zhang, N.; Yuan, R.; Xin, K.Z.; Lu, Z.; Ma, Y. Antimicrobial Susceptibility, Biotypes and Phylotypes of Clinical Cutibacterium (Formerly Propionibacterium) acnes Strains Isolated from Acne Patients: An Observational Study. Dermatol. Ther. 2019, 9, 735–746. [Google Scholar] [CrossRef] [PubMed]
- Dagnelie, M.A.; Corvec, S.; Saint-Jean, M.; Bourdes, V.; Nguyen, J.M.; Khammari, A.; Dreno, B. Decrease in Diversity of Propionibacterium acnes Phylotypes in Patients with Severe Acne on the Back. Acta Derm. Venereol. 2018, 98, 262–267. [Google Scholar] [CrossRef]
- Lee, S.E.; Kim, J.M.; Jeong, S.K.; Jeon, J.E.; Yoon, H.J.; Jeong, M.K.; Lee, S.H. Protease-activated receptor-2 mediates the expression of inflammatory cytokines, antimicrobial peptides, and matrix metalloproteinases in keratinocytes in response to Propionibacterium acnes. Arch. Dermatol. Res. 2010, 302, 745–756. [Google Scholar] [CrossRef]
- Ryu, S.; Han, H.M.; Song, P.I.; Armstrong, C.A.; Park, Y. Suppression of Propionibacterium acnes Infection and the Associated Inflammatory Response by the Antimicrobial Peptide P5 in Mice. PLoS ONE 2015, 10, e0132619. [Google Scholar] [CrossRef] [PubMed]
- Wu, J.; Guo, R.; Chai, J.; Xiong, W.; Tian, M.; Lu, W.; Xu, X. The Protective Effects of Cath-MH With Anti-Propionibacterium Acnes and Anti-Inflammation Functions on Acne Vulgaris. Front. Pharmacol. 2021, 12, 788358. [Google Scholar] [CrossRef] [PubMed]
- Lyte, P.; Sur, R.; Nigam, A.; Southall, M.D. Heat-killed Propionibacterium acnes is capable of inducing inflammatory responses in skin. Exp. Dermatol. 2009, 18, 1070–1072. [Google Scholar] [CrossRef]
- Tsai, H.H.; Lee, W.R.; Wang, P.H.; Cheng, K.T.; Chen, Y.C.; Shen, S.C. Propionibacterium acnes-induced iNOS and COX-2 protein expression via ROS-dependent NF-kappaB and AP-1 activation in macrophages. J. Dermatol. Sci. 2013, 69, 122–131. [Google Scholar] [CrossRef]
- Grange, P.A.; Chereau, C.; Raingeaud, J.; Nicco, C.; Weill, B.; Dupin, N.; Batteux, F. Production of superoxide anions by keratinocytes initiates P. acnes-induced inflammation of the skin. PLoS Pathog. 2009, 5, e1000527. [Google Scholar] [CrossRef]
- Makrantonaki, E.; Ganceviciene, R.; Dessinioti, C.; Feldman, S.; Zouboulis, C. Acne vulgaris. Nat. Rev. Dis. Primers 2015, 1, 15029. [Google Scholar]
- Xu, Y.; Cha, J.-S.; Lee, S.-O.; Ryu, S.-I.; Lee, Y.-K.; Han, H.; Kim, J.-E.; Lee, M.-H.; Lee, E.-O.; Lee, H.-J. HMT Exerts an Anticancer Effect by Targeting PAK-1. Appl. Sci. 2021, 11, 6034. [Google Scholar] [CrossRef]
- Lee, M.-S.; Kim, J.-S.; Cho, S.-M.; Lee, S.O.; Kim, S.-H.; Lee, H.-J. Fermented Rhus verniciflua Stokes extract exerts an Antihepatic Lipogenic effect in oleic-acid-induced HepG2 cells via Upregulation of AMP-activated protein kinase. J. Agric. Food Chem. 2015, 63, 7270–7276. [Google Scholar] [CrossRef] [PubMed]
- Lee, S.-O.; Kim, S.-J.; Kim, J.-S.; Ji, H.; Lee, E.-O.; Lee, H.-J. Comparison of the main components and bioactivity of Rhus verniciflua Stokes extracts by different detoxification processing methods. BMC Complement. Altern. Med. 2018, 18, 242. [Google Scholar] [CrossRef] [PubMed]
- Blois, M.S. Antioxidant determinations by the use of a stable free radical. Nature 1958, 181, 1199–1200. [Google Scholar] [CrossRef]
- Iinuma, K.; Sato, T.; Akimoto, N.; Noguchi, N.; Sasatsu, M.; Nishijima, S.; Kurokawa, I.; Ito, A. Involvement of Propionibacterium acnes in the augmentation of lipogenesis in hamster sebaceous glands in vivo and in vitro. J. Investig. Dermatol. 2009, 129, 2113–2119. [Google Scholar] [CrossRef]
- Iwata, C.; Akimoto, N.; Sato, T.; Morokuma, Y.; Ito, A. Augmentation of lipogenesis by 15-deoxy-Delta12,14-prostaglandin J2 in hamster sebaceous glands: Identification of cytochrome P-450-mediated 15-deoxy-Delta12,14-prostaglandin J2 production. J. Investig. Dermatol. 2005, 125, 865–872. [Google Scholar] [CrossRef]
- Thiboutot, D.; Gilliland, K.; Light, J.; Lookingbill, D. Androgen metabolism in sebaceous glands from subjects with and without acne. Arch. Dermatol. 1999, 135, 1041–1045. [Google Scholar] [CrossRef]
- Seo, Y.J.; Li, Z.J.; Choi, D.K.; Sohn, K.C.; Kim, H.R.; Lee, Y.; Kim, C.D.; Lee, Y.H.; Shi, G.; Lee, J.H.; et al. Regional difference in sebum production by androgen susceptibility in human facial skin. Exp. Dermatol. 2014, 23, 70–72. [Google Scholar] [CrossRef]
- Zouboulis, C.C. The human skin as a hormone target and an endocrine gland. Hormones 2004, 3, 9–26. [Google Scholar] [CrossRef]
- Rosette, C.; Agan, F.J.; Mazzetti, A.; Moro, L.; Gerloni, M. Cortexolone 17α-propionate (Clascoterone) Is a Novel Androgen Receptor Antagonist that Inhibits Production of Lipids and Inflammatory Cytokines from Sebocytes In Vitro. J. Drugs Dermatol. JDD 2019, 18, 412–418. [Google Scholar]
- DeBose-Boyd, R.A.; Ye, J. SREBPs in Lipid Metabolism, Insulin Signaling, and Beyond. Trends Biochem. Sci. 2018, 43, 358–368. [Google Scholar] [CrossRef]
- Vowels, B.R.; Yang, S.; Leyden, J.J. Induction of proinflammatory cytokines by a soluble factor of Propionibacterium acnes: Implications for chronic inflammatory acne. Infect. Immun. 1995, 63, 3158–3165. [Google Scholar] [CrossRef] [PubMed]
- Al-Shobaili, H.A. Oxidants and anti-oxidants status in acne vulgaris patients with varying severity. Ann. Clin. Lab. Sci. 2014, 44, 202–207. [Google Scholar] [PubMed]
- Al-Shobaili, H.A.; Alzolibani, A.A.; Al Robaee, A.A.; Meki, A.R.; Rasheed, Z. Biochemical markers of oxidative and nitrosative stress in acne vulgaris: Correlation with disease activity. J. Clin. Lab. Anal. 2013, 27, 45–52. [Google Scholar] [CrossRef] [PubMed]
- Kavoosi, G.; Ardestani, S.K.; Kariminia, A. The involvement of TLR2 in cytokine and reactive oxygen species (ROS) production by PBMCs in response to Leishmania major phosphoglycans (PGs). Parasitology 2009, 136, 1193–1199. [Google Scholar] [CrossRef] [PubMed]
- Wranicz, J.K.; Cygankiewicz, I.; Rosiak, M.; Kula, P.; Kula, K.; Zareba, W. The relationship between sex hormones and lipid profile in men with coronary artery disease. Int. J. Cardiol. 2005, 101, 105–110. [Google Scholar] [CrossRef] [PubMed]
- Hur, S.; Jang, E.; Lee, J.H. Beneficial Actions of Orostachys japonica and Its Compounds against Tumors via MAPK Signaling Pathways. Nutrients 2021, 13, 555. [Google Scholar] [CrossRef]
- Park, J.-G.; Park, J.-C.; Hur, J.-M.; Park, S.-J.; Choi, D.-R.; Shin, D.-Y.; Park, K.-Y.; Cho, H.-W.; Kim, M.-S. Phenolic compounds from Orostachys japonicus having anti-HIV-1 protease activity. Nat. Prod. Sci. 2000, 6, 117–121. [Google Scholar]
- Park, H.J.; Lee, S.H.; Jang, G.Y.; Li, M.; Kim, M.Y.; Kim, S.T.; Lee, J.H.; Yoon, G.M.; Lee, J.; Jeong, H.S. Phenolic contents of different parts of Rhus verniciflua Stokes according to extraction conditions. J. Korean Soc. Food Sci. Nutr. 2015, 44, 97–103. [Google Scholar] [CrossRef]
- Bai, J.; Zhang, Y.; Tang, C.; Hou, Y.; Ai, X.; Chen, X.; Zhang, Y.; Wang, X.; Meng, X. Gallic acid: Pharmacological activities and molecular mechanisms involved in inflammation-related diseases. Biomed. Pharmacother. 2021, 133, 110985. [Google Scholar] [CrossRef]
- Kim, J.H.; Kim, M.Y.; Kim, J.H.; Cho, J.Y. Fisetin Suppresses Macrophage-Mediated Inflammatory Responses by Blockade of Src and Syk. Biomol. Ther. 2015, 23, 414–420. [Google Scholar] [CrossRef] [PubMed]
- Ghosh, B. Quercetin inhibits LPS-induced nitric oxide and tumor necrosis factor-alpha production in murine macrophages. Int. J. Immunopharmacol. 1999, 21, 435–443. [Google Scholar]
- Tang, X.L.; Liu, J.X.; Dong, W.; Li, P.; Li, L.; Hou, J.C.; Zheng, Y.Q.; Lin, C.R.; Ren, J.G. Protective effect of kaempferol on LPS plus ATP-induced inflammatory response in cardiac fibroblasts. Inflammation 2015, 38, 94–101. [Google Scholar] [CrossRef] [PubMed]
- Kozan, A.; Guner, R.Y.; Akyol, M. A retrospective assessment and comparison of the effectiveness of benzoyl peroxide; the combination of topical niacinamide, gallic acid, and lauric acid; and the combination of benzoyl peroxide and erythromycin in acne vulgaris. Dermatol. Ther. 2020, 33, e13534. [Google Scholar] [CrossRef]
- Yin, J.; Hwang, I.H.; Lee, M.W. Anti-acne vulgaris effect including skin barrier improvement and 5alpha-reductase inhibition by tellimagrandin I from Carpinus tschonoskii. BMC Complement. Altern. Med. 2019, 19, 323. [Google Scholar] [CrossRef]
- Dos Santos, Z.M.Q.; Dos Santos, M.Q.; Zancanaro, V.; Bellaver, E.H.; Nardi, G.M.; Gelinski, J.M.L.; Locatelli, C. Topical application of phenolic compounds suppresses Propionibacterium acnes-induced inflammatory responses in mice with ear edema. Naunyn Schmiedebergs Arch. Pharmacol. 2019, 392, 529–540. [Google Scholar] [CrossRef]
- Amer, S.S.; Mamdouh, W.; Nasr, M.; ElShaer, A.; Polycarpou, E.; Abdel-Aziz, R.T.A.; Sammour, O.A. Quercetin loaded cosm-nutraceutical electrospun composite nanofibers for acne alleviation: Preparation, characterization and experimental clinical appraisal. Int. J. Pharm. 2022, 612, 121309. [Google Scholar] [CrossRef]
- Hosny, K.M.; Al Nahyah, K.S.; Alhakamy, N.A. Self-Nanoemulsion Loaded with a Combination of Isotretinoin, an Anti-Acne Drug, and Quercetin: Preparation, Optimization, and In Vivo Assessment. Pharmaceutics 2020, 13, 46. [Google Scholar] [CrossRef]
- Amer, S.S.; Nasr, M.; Abdel-Aziz, R.T.A.; Moftah, N.H.; El Shaer, A.; Polycarpou, E.; Mamdouh, W.; Sammour, O. Cosm-nutraceutical nanovesicles for acne treatment: Physicochemical characterization and exploratory clinical experimentation. Int. J. Pharm. 2020, 577, 119092. [Google Scholar] [CrossRef]
- Joo, J.H.; Han, M.H.; Kim, J.I.; Kim, J.E.; Jung, K.H.; Oh, H.S.; Chung, Y.S.; An, H.J.; Lee, J.D.; Moon, G.S.; et al. Antimicrobial Activity of Smilax china L. Root Extracts against the Acne-Causing Bacterium, Cutibacterium acnes, and Its Active Compounds. Molecules 2022, 27, 8331. [Google Scholar] [CrossRef]
- Lim, Y.H.; Kim, I.H.; Seo, J.J. In vitro activity of kaempferol isolated from the Impatiens balsamina alone and in combination with erythromycin or clindamycin against Propionibacterium acnes. J. Microbiol. 2007, 45, 473–477. [Google Scholar] [PubMed]
- Park, S.-Y.; So, Y.-J. Cosmetics Material Research of FRO Extract. J. Wellbeing Manag. Appl. Psychol. 2021, 4, 39–44. [Google Scholar]

| Antibody | Company | Dilution | Product No. |
|---|---|---|---|
| p-STAT-3 | Cell Signaling | 1:2000 | 9145 |
| STAT-3 | Cell Signaling | 1:2000 | 12640 |
| p-NF-κB | Cell Signaling | 1:1000 | 3031 |
| NF-κB | Cell Signaling | 1:1000 | 8242 |
| TNF-α | Cell Signaling | 1:1000 | 3707 |
| IL-6 | Cell Signaling | 1:1000 | 12912 |
| SREBP-1 | Santa Cruz | 1:1000 | sc-365513 |
| FAS | Cell Signaling | 1:5000 | 3180 |
| AR | Cell Signaling | 1:1000 | 3202 |
| iNOS | Bioss | 1:1000 | bs-2072 |
| β-actin | Sigma-Aldrich | 1:20,000 | A5316 |
| goat anti-rabbit IgG (HRP) | Abcam | 1:5000 | ab97051 |
| goat anti-mouse IgG (HRP) | Jackson | 1:5000 | 115-035-003 |
| TPC | FRO |
|---|---|
| mg GAE/g | 118.2 ± 3.16 |
Disclaimer/Publisher’s Note: The statements, opinions and data contained in all publications are solely those of the individual author(s) and contributor(s) and not of MDPI and/or the editor(s). MDPI and/or the editor(s) disclaim responsibility for any injury to people or property resulting from any ideas, methods, instructions or products referred to in the content. |
© 2023 by the authors. Licensee MDPI, Basel, Switzerland. This article is an open access article distributed under the terms and conditions of the Creative Commons Attribution (CC BY) license (https://creativecommons.org/licenses/by/4.0/).
Share and Cite
Kim, J.-E.; Han, H.; Xu, Y.; Lee, M.-H.; Lee, H.-J. Efficacy of FRO on Acne Vulgaris Pathogenesis. Pharmaceutics 2023, 15, 1885. https://doi.org/10.3390/pharmaceutics15071885
Kim J-E, Han H, Xu Y, Lee M-H, Lee H-J. Efficacy of FRO on Acne Vulgaris Pathogenesis. Pharmaceutics. 2023; 15(7):1885. https://doi.org/10.3390/pharmaceutics15071885
Chicago/Turabian StyleKim, Jung-Eun, Hengmin Han, Yinzhu Xu, Min-Ho Lee, and Hyo-Jeong Lee. 2023. "Efficacy of FRO on Acne Vulgaris Pathogenesis" Pharmaceutics 15, no. 7: 1885. https://doi.org/10.3390/pharmaceutics15071885
APA StyleKim, J.-E., Han, H., Xu, Y., Lee, M.-H., & Lee, H.-J. (2023). Efficacy of FRO on Acne Vulgaris Pathogenesis. Pharmaceutics, 15(7), 1885. https://doi.org/10.3390/pharmaceutics15071885

